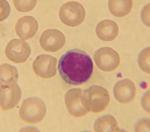

| ||||
Leukocytes, Antibodies & Blood Typing
Laboratory Exercise
Lab #6: Immunology Lab Materials
This is the main page for the Immunology Laboratory Topic of an 8-week introductory college microbiology class. This lab introduces students to leukocytes, antibodies how ABO Rh blood typing works.
Page last updated: 2/2016
SPO VIRTUAL CLASSROOMS
 | ||||||
ADDITIONAL REQUIRED READINGS & ANIMATED LESSONS
- The Immune System in More Detail from Nobelprize.org
- The Immune Response Animation from McGraw-Hill
- Antigenic Determinants (Epitopes) Animation from McGraw-Hill
The Immunology Lab materials of the Virtual Microbiology Classroom include:
- Lab Exercise Instructions
- Lab Report Assignment
- Links to images related to the lab
- Additional articles and links that support the lecture material
NOTE: Students must review all material in categories highlighted with red titles PRIOR TO ATTENDING LAB in order to be prepared to participate.
IMMUNOLOGY LAB DOCUMENTS
The Lab Exercise Instructions are the main resource required for students to understand and complete this exercise. They provide a thorough explanation of the lab topic, as well as detailed directions on how to complete the exercise. The Lab Report Assignment is the homework that students complete and turn in.
- Lab #6: Leukocytes, Antibodies & Blood Typing Lab Exercise INSTRUCTIONS
- Lab #6: Leukocytes, Antibodies & Blood Typing Lab Report ASSIGNMENT
NOBELPRIZE.ORG BLOOD TYPING GAME
ABO BLOOD TYPE CHART
Red Blood Cell
Compatibility Chart
Student blood test: Three drops of blood are mixed with anti-B (left) and anti-A (right) serum. The aagglutination on the right side indicates type A blood.
Back to >
You have free access to a large collection of materials used in a college-level introductory microbiology course. The Virtual Microbiology Classroom provides a wide range of free educational resources including PowerPoint Lectures, Study Guides, Review Questions and Practice Test Questions.